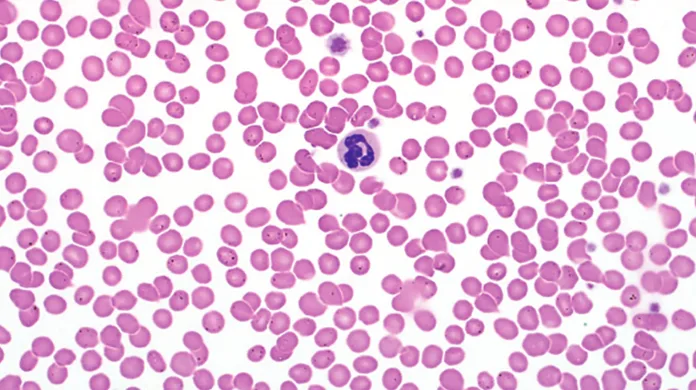

Platelet Estimates from Blood Smears in Dogs
Anne Barger, DVM, MS, DACVP, University of Illinois
In the Literature
Paltrinieri S, Paciletti V, Zambarbieri J. Analytical variability of estimated platelet counts on canine blood smears. Vet Clin Pathol. 2018;47(2):197-204.
The Research …
Platelet estimates from peripheral blood smears are a vital component of a CBC. Automated cell counters do a sufficient job of counting platelets via various methodologies (primarily optical laser and impedance counting), but there are obstacles that limit the reliability of automated platelet counts, such as variation in platelet size and erroneous counting of cell debris, cell fragments, and microcytic RBCs. Platelet clumping can also present a significant challenge to automated platelet counts.
In human medicine, studies have thoroughly evaluated platelet estimation of the blood smear with comparison to automated methods,1,2 but these methods focused on the calculations used rather than the specifics of where to count in the smear. Many veterinary textbooks and review articles indicate platelets should be estimated at 100× oil immersion objective in the body of the smear but do not provide more detail or reference.3,4
In the present study, the precision of platelet estimates from canine blood smears was evaluated in different areas of the smears (ie, lateral edge, central monolayer, feathered edge) by different observers with varying degrees of clinical experience. Each observer evaluated the same 30 blood smears presented in the same type of anticoagulant. It was determined that high variability exists among observers. As historically recommended, the central monolayer appeared to be the best area to gain the greatest agreement among observers. However, as this study points out, greater efforts are needed to standardize platelet estimates, and clinicians should remember that these are estimates and not true platelet counts.
Platelet clump from a canine blood smear. Platelet clumps will interfere with the accurate assessment of automated platelet counts and estimates from a blood smear. Wright-Giemsa stain; 500× total magnification
… The Takeaways
Key pearls to put into practice:
Clinicians should remember that platelet estimates are just estimates and are not adequately precise to be relied on alone when evaluating platelet mass.
Clinicians should be mindful of platelet clumps, which can falsely decrease both automated platelet counts and platelet estimates.